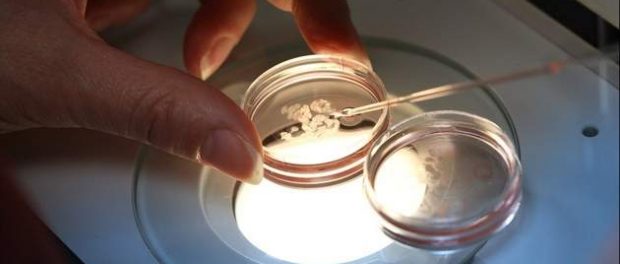
fecondazione in vitro siracusa times
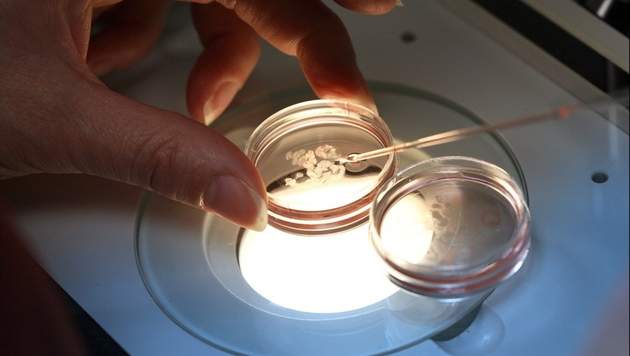

News Catania: pesa 3,2 kg e lui e la sua mamma stanno bene. Il piccolo nato a Catania è il primo bambino concepito con la fecondazione eterologa in tutta l’Isola dopo la sentenza 162/2014 della Corte Costituzionale che ha abolito il divieto posto in essere dalla legge 40 del 2004 (Capo II “Accesso alle tecniche”, art 4, n. 3 “È vietato il ricorso a tecniche di procreazione medicalmente assistita di tipo eterologo“).
News Catania: pesa 3,2 kg e lui e la sua mamma stanno bene. Il piccolo nato a Catania è il primo bambino concepito con la fecondazione eterologa in tutta l’Isola dopo la sentenza 162/2014 della Corte Costituzionale che ha abolito il divieto posto in essere dalla legge 40 del 2004 (Capo II “Accesso alle tecniche”, art 4, n. 3 “È vietato il ricorso a tecniche di procreazione medicalmente assistita di tipo eterologo“).
Con la fecondazione eterologa, nei soli casi di assoluta infertilità, si effettua il ricorso ad un donatore esterno di ovociti o spermatozoi. Proprio tale modalità di intervento rappresenta il discriminante dalla fecondazione omologa che si realizza quando seme e ovulo provengono dalla stessa coppia.
Il Policlinico di Catania vanta una delle strutture più all’avanguardia in campo internazionale, già nel 2000, infatti, l’impianto ospedaliero era stato autore della prima diagnosi genetica preimpianto per la talassemia in Italia. Le fasi del trattamento sono state eseguite ed osservate dall’equipe del Centro Umr (Unità di Medicina della Riproduzione) – Hera di Catania guidato dal ginecologo Nino Guglielmino. Il parto, assistito dal professore Michele Fichera, è poi avvenuto nella Clinica Ostetrica del Policlinico.
La fecondazione eterologa rappresenta ancora oggi, nonostante l’intervento chiarificatore promosso dalla Corte Costituzionale il 9 aprile 2014, una delle questioni tra le più controverse in ambito medico-legale in vista delle notevoli e numerose implicazioni in ordine agli status genitoriali e all’irrinunciabile equilibrio esistente tra diritti personali dei soggetti coinvolti nel trattamento e i modelli familiari ai quali lo stesso può condurre, designando una tematica dalla enorme significatività sociale.